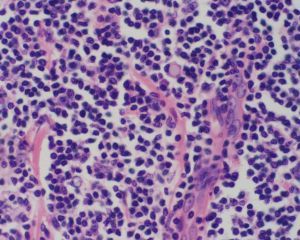
陰道子宮內膜間質肉瘤

簡介
陰道子宮內膜間質肉瘤
陰道子宮內膜間質肉瘤子宮內膜間質肉瘤(endometrialstromalsarcoma)根據惡性程度不同分為低度惡性和高度惡性兩種。低度惡性子宮內膜間質肉瘤以往有很多名稱,曾被稱為間質性子宮內膜異位症、淋巴管內間質肌病、淋巴管內間質異位症、間質肉瘤或苗勒間質肉瘤(mullerianstromalsarcoma)等。
病因病機
病因
陰道子宮內膜間質肉瘤目前病因尚不明了。
病機
瘤組織灰黃色,魚肉狀。局部侵入肌壁時,可呈小團狀突起,質韌如橡皮,富有彈性。部分肌壁增厚。血管內可見蚯蚓狀瘤栓,有彈性。
鏡檢低度惡性子宮內膜間質肉瘤細胞類似於正常增生期子宮內膜間質細胞,其間滿布類似分泌晚期螺鏇動脈的厚壁小血管。細胞為圓形、大小一致的,胞漿少,核深染,核分裂象<3/10HPF,腫瘤細胞侵入淋巴管或血管內形成蚯蚓樣瘤栓。高度惡性者細胞異型性明顯,核分裂象≥10/10HPF。
免疫組化vimentin、CD10呈瀰漫、強陽性表達。ER、PR大部分為陽性,部分desmin陽性。
分類
內膜間質肉瘤(endometriumstromalsarcoma)來自子宮內膜間質細胞,分以下兩類:
a.低度惡性子宮內膜間質肉瘤:可形成息肉狀或結節自宮內膜突向宮腔或突至宮頸口外,腫瘤蒂寬,質軟脆;也可似平滑肌瘤位於子宮肌層內,浸潤子宮肌層,呈結節狀或瀰漫性生長。腫瘤切面質地柔軟,似生魚肉狀,伴出血、壞死時,則可見暗紅、棕褐或灰黃色區域。宮旁組織或子宮外盆腔內可見似蚯蚓狀淋巴管內腫瘤,質如橡皮,富有彈性,此為低度惡性內膜間質肉瘤常見的特徵。鏡下可見瘤細胞象增殖期子宮內膜間質細胞,核分裂像≤5-10/10HPFs,腫瘤內血管較多,腫瘤沿擴張的血管淋巴管生長,呈舌狀浸潤周圍平滑肌組織。雌激素受體(ER)和孕激素受體(PR)可陽性,DNA倍體多為二倍體。
b.高度惡性子宮內膜間質肉瘤:大體形態與低度惡性子宮內膜間質肉瘤相似,但腫瘤體積更大,出血壞死更明顯,有的病灶類似子宮內膜癌和子宮中胚葉混合瘤,缺乏蚯蚓狀淋巴管內腫瘤的特徵。鏡下可見瘤細胞呈梭形或多角形,異型性明顯;核分裂像≥10/10HPFs;瘤細胞可排列成上皮樣細胞巢、索和片狀;瘤細胞可沿淋巴竇或血竇生長或侵入肌層。
低度惡性子宮內膜間質肉瘤發病年齡較年輕,平均發病年齡為34.5歲,而高度惡性者平均年齡為50.8歲。
術前診斷較為困難,常需術中冷凍切片以及術後石蠟病理檢查才能明確診斷。
子宮內膜間質肉瘤可表現為宮頸口或陰道內發現軟脆、易出血的息肉樣腫物,如腫物破潰合併感染,可有極臭的陰道分泌物,也常合併貧血,子宮增大,盆腔腫物。
診斷性刮宮,是早期診斷子宮肉瘤的方法之—,刮宮對子宮內膜間質肉瘤有較大診斷價值。
早期症狀
陰道子宮內膜間質肉瘤大多表現為陰道壁突出的結節狀物,伴陰道出血,白帶增多,也可表現為下腹脹痛,陰道、肛門墜脹,排尿、排便困難。腫塊大小3~10cm,可呈息肉狀,邊界清,質軟,無壓痛,活動或固定。
陰道子宮內膜間質肉瘤可根據臨床症狀、體徵及實驗檢查做出診斷。
治療方法
手術
手術是子宮肉瘤主要治療方法。
手術範圍:筋膜外子宮切除術和雙附屬檔案切除術可同時行盆腔和腹主動脈旁淋巴結切除術。應常規留取腹腔沖洗液進行細胞病理學檢查。對於低度惡性內膜間質肉瘤因其與卵巢分泌激素密切相關,不宜保留卵巢。
放療
放療對子宮內膜間質肉瘤較好。一般認為術後輔助放療,有助於預防盆腔復發,提高5年生存率。一般採用盆腔外照射和陰道內照射。對於復發或轉移的晚期患者,可行姑息性放療。
化療
化療一般主張對高度惡性子宮內膜間質肉瘤以及肉瘤復發患者,可輔助化療。化療以阿黴素的療效最佳,文獻報導單藥有效率為25.0%,而其他有效的藥物有異環磷醯胺、順鉑及依託泊苷等。目前尚無理想的化療方案,下列方案可選用。
常用化療方案:
(1)IAP方案:異環磷醯胺(IFO)(美司鈉解毒)+鹽酸表柔比星(EPI-ADM)+DDP。
(2)HDE方案:羥基脲(Hu)+氮烯米胺(DTIC)+依託泊苷(Vp16)。
孕激素治療:孕激素類藥物主要用於治療低度惡性內膜間質肉瘤及部分孕激素受體陽性(PR)的高度惡性內膜間質肉瘤,對於孕激素受體陽性患者,孕激素類藥物有較好的反應。
檢查
免疫組化檢查、組織病理學檢查。
陰道鏡檢查。
預防
1.調護情志,遇事達觀。
2.適時婚嫁,生兒育女。
3.切勿濫用激素類藥物。
4.定期檢查身體,發現疾病及早治療。
護理
子宮肉瘤是一種少見的女性生殖器官惡性腫瘤,占子宮惡性腫瘤的2%-4%,占生殖道惡性腫瘤的1%。惡性程度很高,多見於絕經前後的婦女。這種腫瘤來源於中胚層,可來自子宮的肌肉、結締組織、血管、內膜基質或肌瘤。組織學起源多是子宮肌層,亦可是肌層內結締組織或子宮內膜的結締組織。發病率大約在20%-40%左右,多見於30-50歲的婦女,肉瘤可見於子宮各個部位,宮體部遠較宮頸部常見約為15:1。子宮肉瘤占子宮惡性腫瘤的2-5%,好發年齡為50歲左右,而宮頸葡萄狀肉瘤多見於幼女。因早期無特異症狀,故術前診斷率僅30-39%。
預後
陰道子宮內膜間質肉瘤預後較其他肉瘤相對好,雖然各報導隨訪時間6月~13年不等,但未見死於該瘤的報導,僅1例報導在術後6個月轉移至盆腔和肺。Chang等和陶淑芸等在術後分別隨訪1.5年、2年,均未見復發或轉移。Peters等(1985)報導1例在後盆腔除髒術後隨訪13年無瘤生存。
食療
陰道子宮內膜間質肉瘤食療
1)、二鮮湯
具體的做法是,把鮮藕120克切片、鮮茅根120克切碎,用水煮汁當茶飲。
功效:滋陰涼血,祛淤止血。適宜月經量多,血熱淤阻型。
2)、消瘤蛋
所需材料:雞蛋2個、中藥壁虎5隻、莪術9克,加水400克共煮。做法:待蛋熟後剝皮再煮,棄藥食蛋,每晚服1次。
功效:散結止痛,祛風定驚。適宜氣滯血淤型。
3)、銀耳藕粉湯
所需材料:銀耳25克、藕粉10克、冰糖適量。具體的做法:銀耳泡發後加適量冰糖燉爛,入藕粉沖服。
功效:有清熱潤燥止血的功效。適宜月經量多,血色鮮紅者。
注意事項
陰道子宮內膜間質肉瘤患者吃什麼好?
(1)宜吃薊菜、甜瓜、菱、薏米、薜荔果、烏梅、牛蒡菜、牡蠣、甲魚、海馬。
(2)出血宜吃魚翅、海參、鮫魚、黑木耳、香菇、蘑菇、淡菜、蠶豆。
(3)水腫宜吃鱘魚、石蓴、赤豆、玉蜀黍、鯉魚、鯪魚、泥鰍、蛤、胰魚、鴨肉、萵苣、椰子漿。
(4)腰痛宜吃蓮子、核桃肉、薏米、韭菜、梅子、栗子、芋艿、甲魚、海蜇、蜂乳、鱟、梭子蟹。
(5)白帶多宜吃烏賊、淡菜、文蛤、蟶子、牡蠣、龜、海蜇、羊胰、雀、豇豆、白果、胡桃、蓮子、芡實、芹菜。
(6)防治化療、放療副作用的食物:豆腐、豬肝、青魚、鯽魚、墨魚、鴨、牛肉、田雞、山楂、烏梅、綠豆、無花果。
陰道子宮內膜間質肉瘤患者吃什麼對身體不好?
(1)忌煙、酒及辛辣刺激性食物。
(2)忌肥膩、油煎、霉變、醃製食物。
(3)忌羊肉、韭菜、狗肉、胡椒、姜、桂皮等溫熱性食物。
(4)忌公雞等發物。
治療用藥
中文名稱 鯊肝醇片
產品英文名稱 BatilolTablets
生產企業 江蘇吳中醫藥集團有限公司蘇州第六製藥廠
功效主治 1.用於治療各種原因引起的白細胞減少症,如放射性、抗腫瘤藥物等所致的白細胞減少症。2.用於治療不明原因所致的白細胞減少症。
中文名稱 複方環磷醯胺片
生產企業 天津金世製藥有限公司
功效主治 抗腫瘤藥。主用於惡性淋巴瘤、急性淋巴細胞白血病、肺癌、各種肉瘤、實體瘤及卵巢癌。
化學成分 本品為複方製劑,其組分為環磷醯胺(C7H15Cl2N2O2P•H2O)50mg,人參莖葉總皂苷50mg。
藥理作用 本品在體外無抗腫瘤活性,進入體內後先在肝臟中經微粒體功能氧化酶轉化成醛磷醯胺,而醛磷醯胺不穩定,在腫瘤細胞內分解成磷醯胺氮芥及丙烯醛,磷醯胺氮芥對腫瘤細胞有細胞毒作用。環磷醯胺是雙功能烷化劑及細胞周期非特異性藥物,可干擾DNA及RNA功能,尤其對前者的影響更大,它與DNA發生交叉聯結,抑制DNA合成,對S期作用最明顯。
中文名稱 依託泊甙軟膠囊
生產企業 青島海爾藥業有限公司
功效主治 主要用於治療小細胞肺癌,惡性淋巴瘤,惡性生殖細胞瘤,白血病,對神經母細胞瘤,橫紋肌肉瘤,卵巢癌,非小細胞肺癌,胃癌和食管癌等有一定療效。
醫學疾病任務——婦科
| 婦科是醫療機構的一個診療科目,是婦產科的一個分支專業,是以診療女性婦科病為診療的專業科室。女性生殖系統所患的疾病才叫婦科疾病。婦科疾病的種類可分很多種,本任務包含大多數婦科疾病。 |

